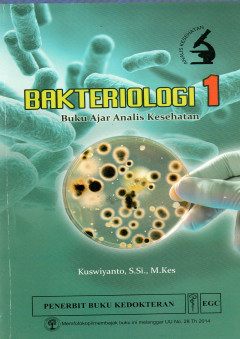
cover

Filter by
Found 2 from your keywords: author=Kuswiyanto

Bakteriologi 1 : Buku Ajar Analis Kesehatan
- Edition
- -
- ISBN/ISSN
- 9789790446083
- Collation
- xi, 146
- Series Title
- -
- Call Number
- 616.92 Kus b
- Edition
- -
- ISBN/ISSN
- 9789790446083
- Collation
- xi, 146
- Series Title
- -
- Call Number
- 616.92 Kus b
Buku Ajar Virologi Untuk Analis Kesehatan
- Edition
- -
- ISBN/ISSN
- 9789790446694
- Collation
- xii, 188
- Series Title
- -
- Call Number
- 614.4 Kus b
- Edition
- -
- ISBN/ISSN
- 9789790446694
- Collation
- xii, 188
- Series Title
- -
- Call Number
- 614.4 Kus b
 Computer Science, Information & General Works
Computer Science, Information & General Works  Philosophy & Psychology
Philosophy & Psychology  Religion
Religion  Social Sciences
Social Sciences  Language
Language  Pure Science
Pure Science  Applied Sciences
Applied Sciences  Art & Recreation
Art & Recreation  Literature
Literature  History & Geography
History & Geography